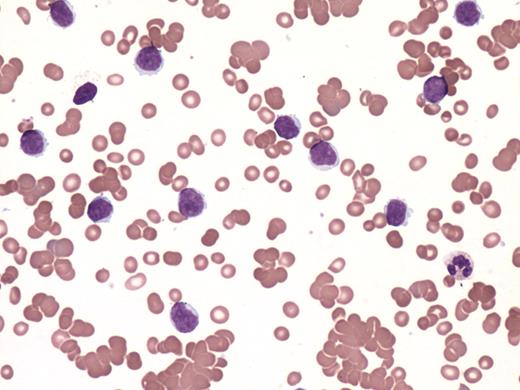
graphic

A 46-year-old man presented with 2 weeks of lethargy and exertional dyspnea. Clinically he was jaundiced and had an enlarged spleen with its edge palpable at 5 cm below the left costal margin. Complete blood count showed hemoglobin of 7.2 g/dL, white cell count of 42.8 × 109/L, 60% of which were prolymphocytes, and platelet count of 150 × 109/L. Aside from the numerous prolymphocytes detected on blood smear, there was marked red cell agglutination (see figure). Hemolysis was evident with elevated reticulocyte count (5.2%), raised serum bilirubin (33μM), low serum haptoglobin (0.1 g/L), and high serum lactate dehydrogenase. Direct Coombs test was strongly positive for C3d. Cold agglutinin was detected to a titer of 1:1024 with anti-I specificity. The serum IgM level was elevated (10.24 g/L) with normal serum IgG and IgA levels; however, a serum electrophoresis was not performed. These findings were consistent with cold agglutinin hemolytic anemia.
Bone marrow revealed 50% prolymphocytes. Immunophenotyping positivity for CD5, CD19, CD23, CD79b, and FMC7 with moderate SmIg expression and κ light chain restriction was consistent with B-cell prolymphocytic leukemia. After combination chemotherapy of rituximab, fludarabine, and cyclophosphamide, the white cell count normalized with a disappearance of prolymphocytes and hemoglobin level that became normal. The peripheral smear no longer showed agglutination, and tests of hemolysis including the Coombs test became negative. This case illustrates the recognition of cold agglutinin hemolytic anemia by a review of the peripheral smear. While cold agglutinin hemolytic anemia is well recognized with chronic lymphoid malignancies, its association to prolymphocytic leukemia is rare.
For additional images, visit the ASH IMAGE BANK, a reference and teaching tool that is continually updated with new atlas and case study images. For more information visit http://imagebank.hematology.org.